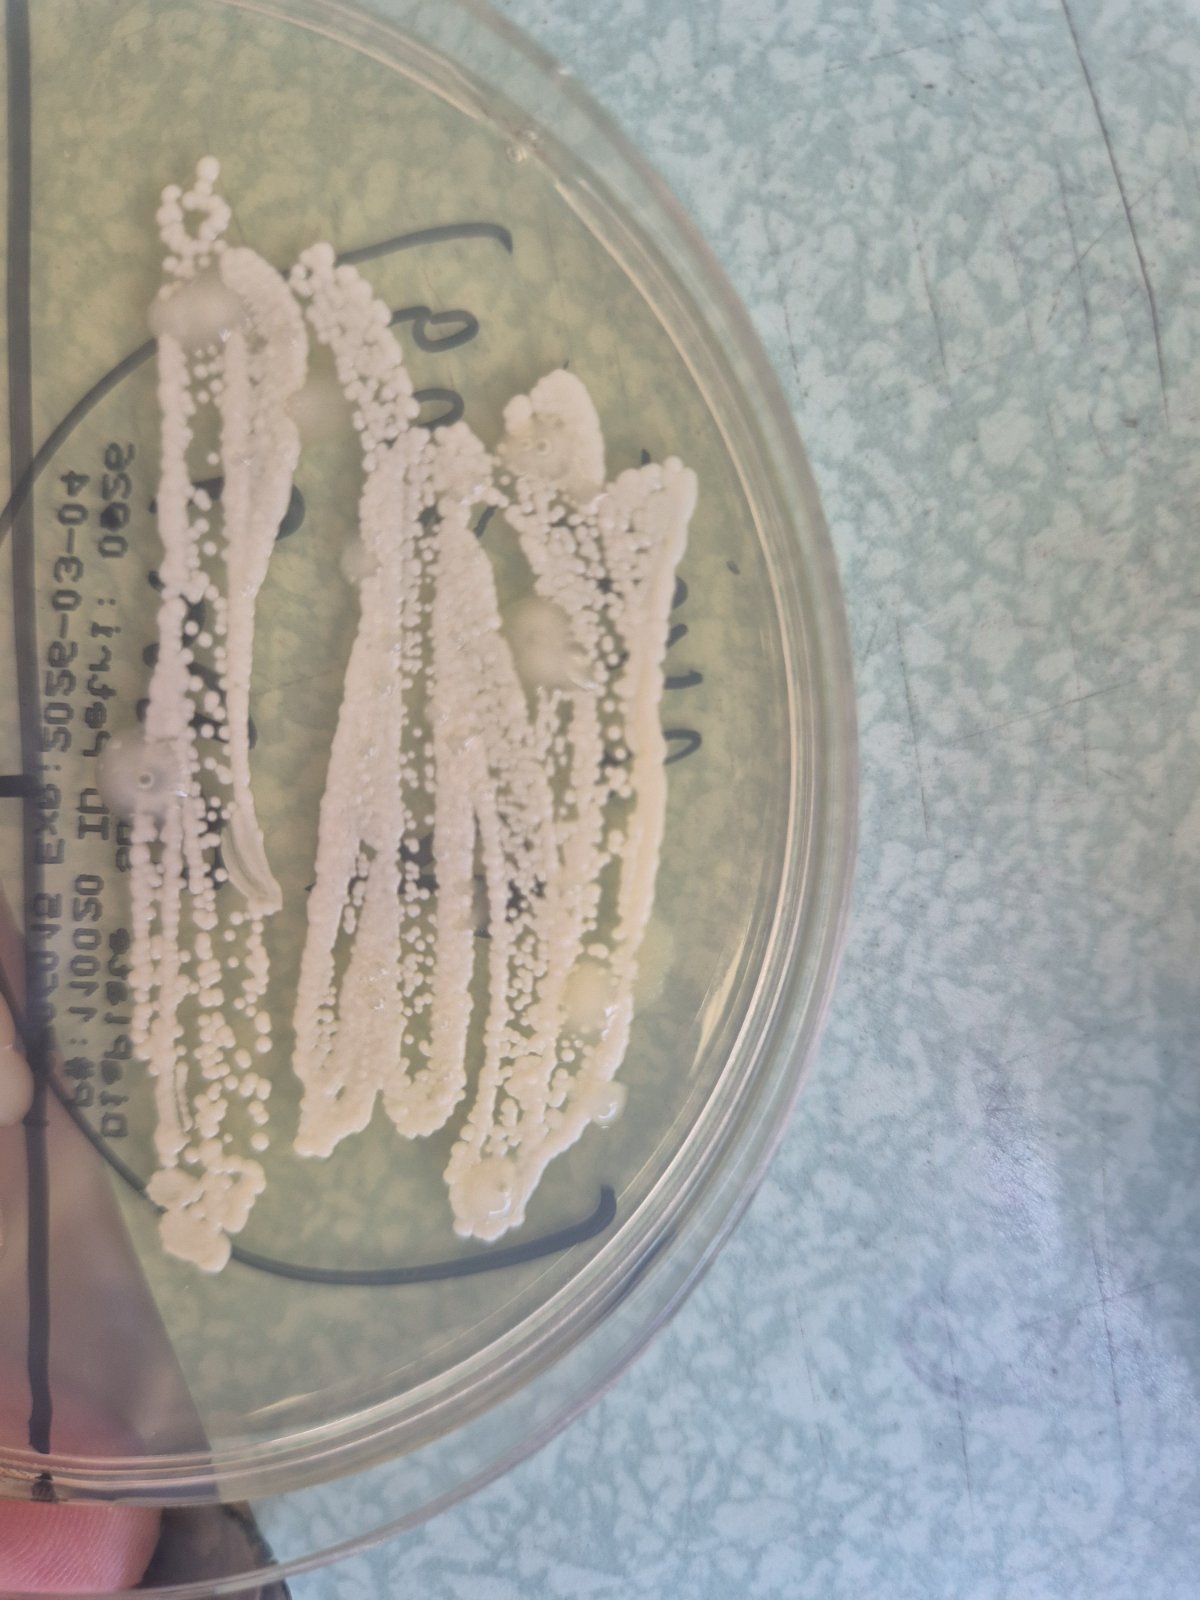
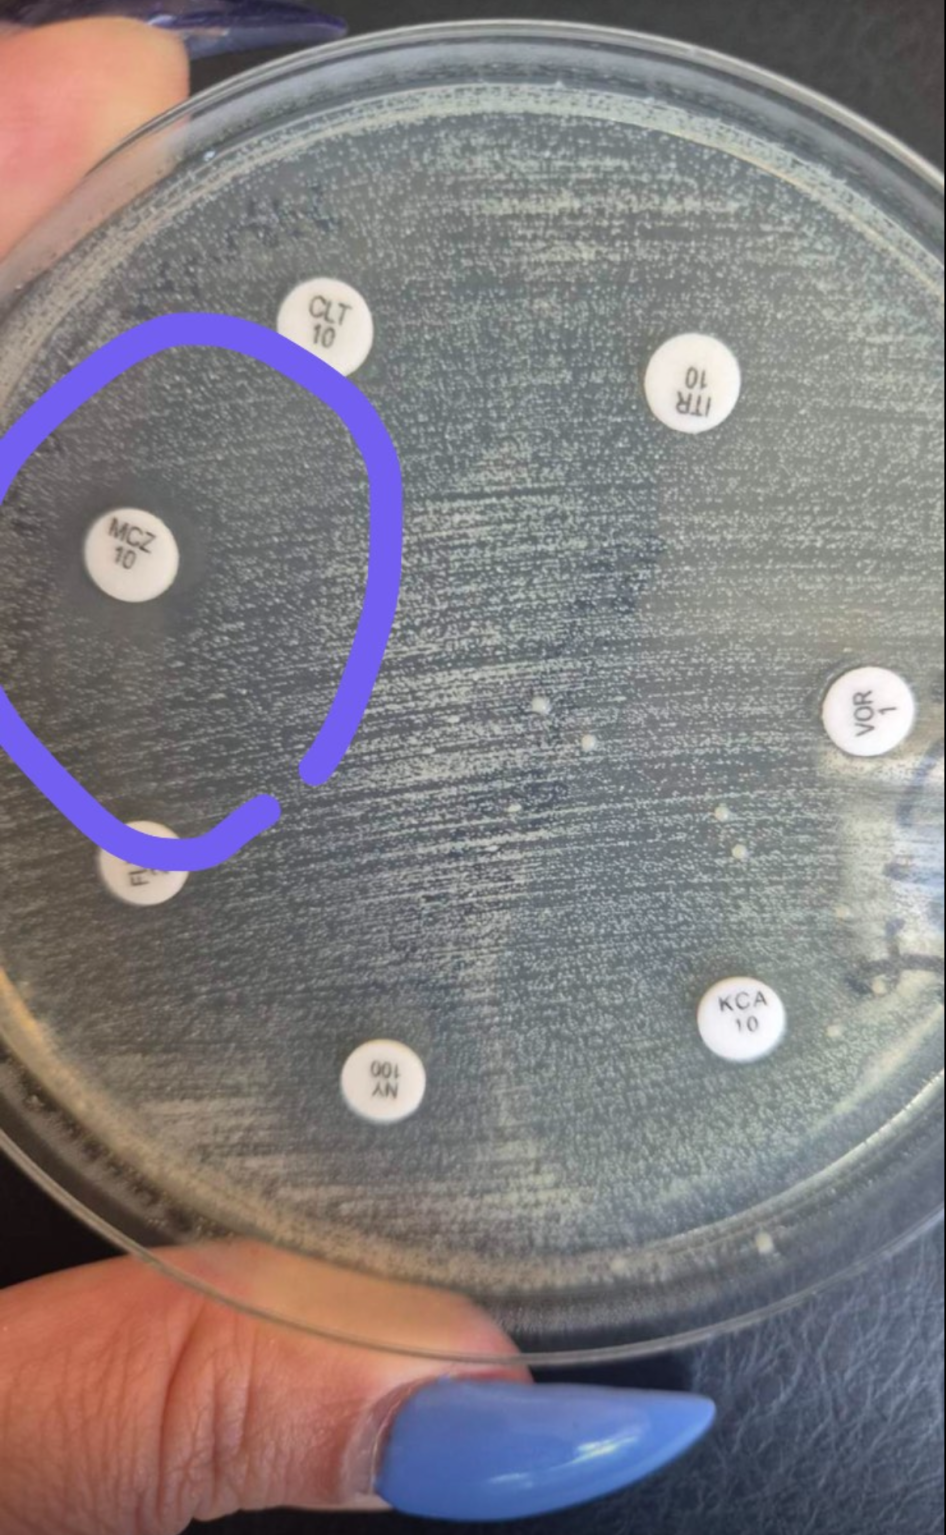

Препоръчвам ти да ти направиш по-пълно изследване - като включиш и ППБ. Вече не смея да препоръчвам лаборатории, защото всичките се дънят, но в твоя случай - направи си един Фемифлор, защото на обикновените МБ не винаги се хваща всичко. Важно е, за да се знае дали няма свръхрастеж на нещо, което тук не се хваща, съответно лечението да е по-различно от само пробиотици. Или пък да има някоя скрита ППБ, която досега да е протичала безсимптомно, но вече да се проявява, има много такива случаи.
- Публикувана: 2 авг. 2025, 19:33 ч.
- Последно мнение: 20 окт. 2025, 17:26 ч.
Гъбички! Писна ми… почвам да се лекувам сама - 17
Препоръчвам ти да ти направиш по-пълно изследване - като включиш и ППБ. Вече не смея да препоръчвам лаборатории, защото всичките се дънят, но в твоя случай - направи си един Фемифлор, защото на обикновените МБ не винаги се хваща всичко. Важно е, за да се знае дали няма свръхрастеж на нещо, което тук не се хваща, съответно лечението да е по-различно от само пробиотици. Или пък да има някоя скрита ППБ, която досега да е протичала безсимптомно, но вече да се проявява, има много такива случаи.
Здравей, пих какво ли не и накрая започнах Интраконазол 400 мг еднократно само и гъба вече нямам. Така ме посъветва фармацевт.
На секрет вече гъба нямам, но имам др вид гадове, които боря.
Няма как от тогава до сега да има промяна, защото съм си с един партньор, който също се е изследвал и при него нищо не е излизало.
Явно е България няма такава диагноза, а само в останалия свят.
Благодаря ти все пак 🤗
Добре, ако отпадат ППБ, то тогава ти предлагам, ако си от София да си пуснеш едно изследване в НЦЗПБ. Понякога там намират неща, които другите лаборатории не откриват.
А вагинална дисбиоза, дисбактериоза, наречи го както искаш не е някаква чужбинска диагноза, която тук е мега неизвестна. Да не казвам, че почти няма жена, която да не е била с такова неща, особено както пием АБ за щяло и нещяло.
Това е просто нарушен дисбаланс на пропорциите на нормално живеещите във влагалището микроорганизми. Трябва да преобладават лактобацилите, а болестотворните бактерии да са в незначително количеството. Когато това равновесие се наруши - тогава се получава дисбиоза, но от твоето изследване аз лично не виждам да е толкова страшно - имаш лактобацили, макар и умерено количество, няма преобладаващ друг микроорганизъм, за да има реално инфекция, няма гъбички. Нищо от това не води до симптоматиката, за която ти се оплакваш. Това ме навежда на мисълта, че проблемът или е другаде, или има нещо неоткрито.
С предишна бременност съм имала веднъж само симптоми на гъбички и ми дадоха Макмирор, но бях в последни месеци. Повече не съм имала проблеми. Сега не знам как да процедирам. Моля за съвети. Благодаря.
Направи си консултация с още 1 АГ, за да ти изпише нещо друго.

Здравейте. Някой лекувал ли е Candida Parapsilosis
Откри ми я д-р Боянова НЦЗПБ
Лечението беше 7 дни мак мирор
После на седмица х 1 за 4 седмици.
Обаче отново я имам
Слабо реагира на миконазол
И на нищо друго.
Не знам какво да приложа
Мажа с клотримазол и миковаГ , който има борна киселина уж за такива резистентни, но ефект няма.
Симптоми. Парене и силен сърбеж
Моля за споделен опит
Преди да забременея, по време на опитите имах доста често гъбички , най-често ми e излизала Albicans. По време на бременността също лекувах тази гъба с полижинакс. След като родих нямах проблем 10 месеца, докато не правихме секс без презерватив и след няколко дни положението се влоши - сърбеж, пресечена история и тн. Моят Аг назначи от разстояние полижинакс, като преди да се консултирам пих един микомакс, който облекчи леко положението, но не напълно. След курса полижинакс съм по-добре, но все още имам леко течение и лек сърбеж от време на време. Започнах да слагам гинофилус , тъй като четох , че е ок след полижинакс да възстановя флората.
Въпроса ми е според вас какви изследвания и къде да пусна , както и мъжа ми за да се изчистим , тъй като предполагам , че той е преносителя.
Благодаря!
Ако искаш - мога да ти дам координати на лекарката, но ми пиши ЛС, защото не искам да ѝ слагам личния телефон във форума.
Вариант 2 - кожно-венерическия диспансер в София, аз лично ходя при д-р Рачева. Тя преглежда и мъже, и жени (дерматовенеролог е), взима и необходимите проби.
На въпроса - и теб те пращам в НЦЗПБ при д-р Боянова. Да, пак ще трябва да дойдеш до София, но ти гарантирам, че няма да те претупа за 5 мин., ще ти направят нужните изследвания и ще ти назначи схема. Ако се налага, тук ще допълваме с някакви идеи за пробиотици и други добавки.
Пиши ми на ЛС, ще ти дам телефона ѝ, за да се разберете кога да отидеш и всичко там, което те интересува.

Аз лично не бих си направила трансфер при активна инфекция. Бих се излекувала и чак на чисти резултати бих го направила.
Хубавата новина е, че са чувствителни на доста неща.
Аз лично залагам на схема с Итраконазол орално + Нистатин вагинално. Освен в Полижинакс, Нистатин има и в Макмирор, който е по-щадящ вариант в случая. Най-добре е иначе чист Нистатин, аптека Ерудита в София със сигурност прави такива глобули, но трябва рецепта от лекар.
Партньорът да се изследва и лекува успоредно с теб.
